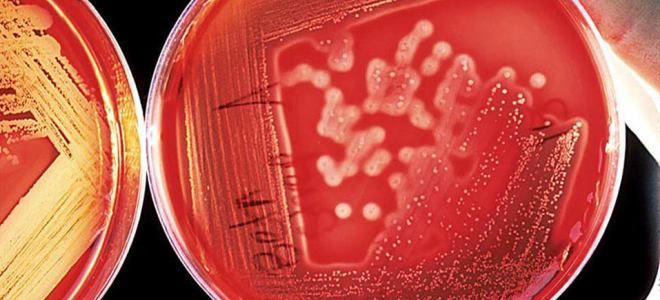
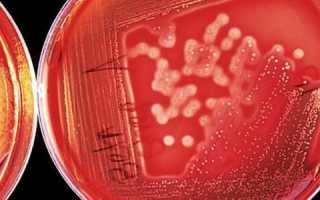

Ureaplasma urealyticum (уреаплазма уреалитикум) — уникальный представитель микрофлоры человека, занимающий промежуточное положение между вирусами и бактериями. Уреаплазма – внутриклеточный паразит, относящийся к семейству микоплазм. Это самые мелкие из свободно живущих микроорганизмов, лишенные клеточной стенки. С бактериями микроб схож некоторыми особенностями обмена веществ, а с вирусами – генетическим аппаратом и размером.
У человека вызвать развитие патологического процесса способны только два вида данного рода: ureaplasma urealiticum и ureaplasma parvum. Областью обитания данных микробов является мочеполовая сфера. В более редких случаях микроорганизм обнаруживают в ткани легких и почек.
Ureaplasma urealyticum и ureaplasma parvum вызывают уреаплазмоз. Это заболевание чаще диагностируется у женщин, поскольку у мужчин острые симптомы обычно отсутствуют. Уреаплазмоз относится к венерическим заболеваниям, передающимся половым путем. У женщин чаще обнаруживают одного возбудителя, а в редких случаях – сразу два, что позволяет дать заключение о наличии ureaplasma spp. Ureaplasma parvum обладает более выраженными патогенными свойствами, чем ureaplasma urealyticum. Лечение инфекции, вызванной ureaplasma parvum, более сложное и длительное, риск развития осложнений очень высок.
Уреаплазменая инфекция в настоящее время широко распространена. Специалисты отмечают высокую степень колонизации мочеполовых органов ureaplasma urealiticum: у мужчин — 25%, у женщин — до 60%.
Что такое уреаплазма?
Уреаплазма – мелкие бактерии, принадлежащие роду микоплазм. По своим размерам они сравнимы с вирусами, а по свойствам занимают промежуточное положение между одноклеточными микроорганизмами и вирусами. Уреаплазма является мембранным паразитом. В ее строении выделяют сложную трехслойную мембрану, которая напоминает микрокапсулу. При этом клеточная стенка, как у бактерий, отсутствует. Это отчасти помогает патогену легче проникать в слизистую оболочку и делает уреаплазму не такой уязвимой. Усиленное размножение провоцирует уреаплазмоз у женщин.
Какие виды уреаплазмы бывают?
Название «уреаплазма» обусловлено способностью расщеплять мочевину в моче с помощью вырабатываемого фермента – уреазы. Данный род микроорганизмов хорошо изучен. Специалисты, описывая патогены по их свойствам, строению, выделяют следующие виды уреаплазмы:
- Ureaplasma canigenitalium;
- Ureaplasma cati;
- Ureaplasma diversum;
- Ureaplasma felinum;
- Ureaplasma gallorale;
- Ureaplasma urealyticum;
- Ureaplasma parvum.
Учитывая все разнообразие этих микроорганизмов, большое клиническое значение имеют две основные разновидности уреаплазмы: парвум и уреалитикум. Непосредственно эти виды провоцируют развитие уреаплазмоза у женщин. Стоит отметить, что каждый из видов имеет еще по несколько серотипов, которые отличаются составом белков и мембранами.
Пути передачи уреаплазмы
Рассматривая такое заболевание, как уреаплазмоз, пути заражения им, на первое место врачи выдвигают половой. Непосредственно во время сексуального контакта в большинстве случаев происходит передача патогена от носителя здоровому партнеру. При этом нельзя исключать и вертикального пути инфицирования, когда уреаплазма у женщин размножившись и поразив всю репродуктивную систему, проникает в организм новорожденного во время продвижения по родовым путям матери. Среди редких, но возможных способов передачи возбудителя:
- контактно-бытовой;
- внутриутробный;
- при трансплантации от инфицированного донора.
Инкубационный период и как передается бактерия
Дриц Ирина Александровна. Врач-паразитолог Гельминтозы могут привести к многочисленным проблемам со здоровьем, сокращающие жизнь на 15-25 лет. Многие паразиты крайне трудно обнаружимы. Они могут быть где угодно — в крови, кишечнике, легких, сердце, мозге. Симптомы глистной инвазии можно спутать с ОРВИ, болезнями ЖКТ и другими. Основная ошибка в таких случаях — затягивание! Если у вас есть подозрения на наличие паразитов, то нужно обратиться к специалисту. Если же говорить о лекарствах и самостоятельном лечении, то от наиболее распространенных гельминтов (аскарид, остриц, цепней) подойдет этот антипаразитный комплекс.
Инкубационный период может длиться от 1 недели до 1 месяца. Даже при отсутствии симптомов, зараженный человек может передавать возбудителя своим половым партнерам.
Наиболее распространенным способом передачи является половой контакт (генитальный, анальный). Для инфицирования требуется минимальное количество бактерий. С невысокой вероятностью возможна инвазия при оральном сексе.
Уреаплазма уреалитикум не передается при:
- поцелуях;
- использовании одного полотенца, посуды;
- посещении общественных бань, бассейнов;
Важно! Домашние животные не являются потенциальными носителями этой инфекции.
Уреаплазма у женщин – причины возникновения
Пытаясь выяснить, из-за чего возникает уреаплазма у женщин, причины ее появления врачи связывают зачастую с ранним началом половой жизни. Современные девушки имеют первый сексуальный опыт в 17-18 лет, когда влагалищная микрофлора не успевает достигнуть необходимого равновесия. Это способствует снижению защитных сил организма, что провоцирует усиленное размножение уреаплазмы. Среди других факторов, повышающих риск развития заболевания:
- частые стрессовые ситуации, снижающие иммунитет;
- период беременности;
- дисбактериоз кишечника;
- длительное применение антибактериальных средств, гормонов;
- тяжелый физический труд, вызывающий хроническую усталость, в результате чего снижаются защитные силы организма.
Уреаплазма у женщин – симптомы
Когда развивается уреаплазмоз у женщин, симптомы заболевания поначалу напоминают уретрит, который не выделяется специфической клиникой. Изредка отмечается подъем температуры тела, ухудшение общего самочувствия. Стоит отметить, что симптоматика появляется не сразу после заражения, а спустя 3-4 недели с момента проникновения уреаплазмы в организм. Продолжительность инкубации определяется состоянием иммунной системы.
Нередко уреаплазма у женщины присутствует не проявляясь, поэтому многие являются носительницами, ничего не подозревая об этом. Только при снижении иммунитета начинается невыраженный, медленнотекущий воспалительный процесс. Одним из главных симптомов уреаплазмоза являются необильные выделения из влагалища серозно-гнойного характера. Если в организме активно размножается уреаплазма симптомы наблюдаются следующие:
- болями внизу живота по типу рези;
- частыми позывами к мочеиспусканию;
- болезненными ощущениями во время мочеиспускания;
- неприятными ощущениями во время полового акта;
- отеком и покраснением слизистой влагалища и шейки матки.
Пути передачи
Уреаплазма у женщин встречается значительно чаще, чем у мужчин (у них наблюдается склонность к самоизлечению), поэтому основными носителями инфекции считаются они. Среди всех путей передачи лидирует половой – среди всех зараженных около 80% это лица, имеющие сексуальные контакты, особенно без постоянного партнера. Передача возбудителя уреаплазмоза возможна и при незащищенном вагинальном половом акте, и при оральном. Бактерии присутствуют:
- у женщин – в секрете цервикального канала, влагалища;
- у мужчин – в секрете простаты, уретре, сперме.
Некоторые врачи предполагают возможность инфицирования контактно-бытовым путем: через предметы личной гигиены больного, но теория пока не получила должного подтверждения. Заразиться в бане, бассейне и остальных местах общего пользования почти невозможно. Помимо этого, существует еще несколько путей, которые актуальны для детского инфицирования:
- Во время родов, при прохождении через родовые пути – так заражаются маленькие дети (30% новорожденных девочек получают уреаплазмоз), даже если мать не испытывает симптоматики уреаплазмоза.
- Через околоплодные воды (внутриутробно через плаценту) – бактерии будут обнаружены в ротовой полости, носоглотке, конъюнктиве. Инфицирование преимущественно происходит в 1-ом триместре беременности, когда болезнь обостряется у матери.
Чем опасна уреаплазма у женщин?
Чтобы понять всю серьезность заболевания, необходимо знать, чем опасна уреаплазма и каковы ее последствия. Усиленное размножение патогенных бактерий приводит к развитию воспалительного процесса. Начинаясь во влагалище, при отсутствии должной терапии воспаление распространяется восходящим путем на шейку матки, сам детородный орган и его придатки. Характер осложнений определяется типом уреаплазмы, спровоцировавшим заболевание.
Уреаплазма парвум
Уреаплазма парвум у женщин входит в состав микрофлоры влагалища. Ее присутствие наблюдается у 50-75 % представительниц прекрасного пола. Длительное время уреаплазма у женщин не провоцирует развитие заболевания, однако снижение иммунитета может привести к ее усиленному размножению, что вызывает патологию. В большинстве случаев парвум провоцирует вялотекущее заболевание по типу уретрита или вагинита, которое ликвидируется при своевременном принятии мер.
Уреаплазма уреалитикум
Непосредственно данный тип уреаплазмы провоцирует урогенитальный уреаплазмоз. Данные условно патогенные микроорганизмы способны паразитировать на поверхности слизистой оболочки мочеполовой системы. В большинстве случаев это проявляется в развитии негонококкового уретрита, реже приводит к циститу (воспалению мочевого пузыря).
Длительное присутствие возбудителя в мочеполовой системе способно провоцировать снижение местного иммунитета, вызывая эндометрит, аднексит. Подобные изменения в репродуктивной системе могут вызвать развитие внематочной беременности, а в тяжелых случаях приводят ко вторичному бесплодию.
Уреаплазма специес
Уреаплазмы species длительное время могут практически незаметно присутствовать в составе микрофлоры влагалища. Однако сопутствующие инфекции, иммунодефициты, снижение местного иммунитета способствуют быстрому размножению уреаплазм и провоцируют развитие уреаплазмоза в течение нескольких дней.
Уреаплазма у женщин данный патоген нередко выступает в качестве возбудителя вагинита, цервицита. Кроме того, при обследовании пациентов с эндометритом, аднекситом врачи также устанавливают причастность к патологии уреаплазмы специес. Данные заболевания грозят многочисленными осложнениями. Самые опасные, которые провоцирует уреаплазма последствия:
- внематочная беременность;
- спаечный процесс в органах малого таза;
- бесплодие.
Уреаплазма уреалитикум: какие иммуноглобулины определяются в крови
Ещё одним методом диагностики уреаплазмоза является анализ крови на антитела.
Это вспомогательный тест, а не основной.
Он может применяться лишь:
- в рамках скрининга – для массового обследования женщин;
- для уточнения характера течения инфекции (вместе с ПЦР).
Для скрининга кровь обычно берут сразу на несколько инфекций.
Если к каким-либо из них, включая уреаплазмоз, выявляются антитела, диагноз не ставится.
Требуется подтверждающий тест.
Таковым может быть ПЦР или бакпосев.
Анализ крови на антитела к уреаплазме применяется для уточнения данных других исследований.
В частности, метод позволяет установить давность инфицирования и активность воспалительного процесса.
Для этого определяются в крови иммуноглобулины разных классов, обычно М и G.
Антитела класса М начинают определяться в крови в небольших титрах уже через неделю после заражения женщины уреаплазмой.
Через 2 месяца они исчезают.
Иммуноглобулины G появляются через 2 недели в крови.
Их титр постепенно нарастает.
После затухания активной фазы инфекции титр снижается.
Но полностью G не исчезают до тех пор, пока есть в организме уреаплазма.
Даже после излечения иммуноглобулины G выявляются в течение нескольких месяцев, а иногда определяются ещё несколько лет.
Таким образом, выводы на основании анализов можно сделать следующие:
- При наличии IgМ и отсутствии IgG – инфицирование произошло совсем недавно, сейчас идет инкубационный период.
- При наличии IgG и IgМ – острая фаза инфекции, с момента заражения прошло не больше 2 месяцев.
- При наличии IgG и отсутствии IgМ – хроническая или перенесенная в недавнем прошлом инфекция.
- При отсутствии обоих классов иммуноглобулинов – инфекции нет, либо заражение произошло меньше 1 недели назад.
Оценивается также уровень IgG в динамике.
При его возрастании в течение 2 недель в 4 раза говорят об активной уреаплазменной инфекции.
Результаты анализов крови не всегда достоверны.
Иногда они дают ложноположительные или отрицательные результаты.
Сроки появления антител тоже могут отличаться у некоторых людей.
Особенно в случае наличия ВИЧ или других иммунодефицитов.
Диагностика уреаплазмы у женщин
Путем оценки одной клинической картины невозможно выставить диагноз уреаплазмоз: симптомы заболевания сходны с проявлениями других гинекологических патологий. Для диагностики присутствия в организме женщины уреаплазм может использоваться несколько методик:
- бактериологический посев на питательные среды;
- ПЦР (полимеразно-цепная реакция);
- ИФА (иммунно-ферментный анализ).
Посев на уреаплазму требует некоторого времени для получения результатов, поэтому врачи отдают предпочтение ПЦР. С помощью этого исследования можно обнаружить присутствие в образце материала молекулы генетического материала, как жизнеспособных, так и погибших уреаплазм (невозможно при бакпосеве). Кроме факта наличия с помощью данного лабораторного исследования можно определить непосредственно тип уреаплазмы, что имеет важное значение при назначении лекарств и разработке плана терапии.
Уреаплазма у женщин – норма
Сразу необходимо отметить, что все результаты исследований объективно оценить способен только специалист. Врачи не просто сопоставляют полученные значения с нормой, но и учитывают общее состояние, которое провоцируют уреаплазмы у женщины, наличие сопутствующих патологий. При этом важное значение имеет время проведения анализа: в течение менструального цикла концентрация условно патогенной микрофлоры способна изменятся в 100-1000 раз.
Чтобы получить объективные результаты, и выявить присутствует ли уреаплазма у женщин анализ назначают на время, когда концентрация их максимальная: 4-7-й день менструального цикла или 21-28-й день. При этом устанавливают общую концентрацию: urealyticum, parvum, ureaplasma spp у женщин, норма содержания которых следующая:
- меньше 104 КОЕ/мл – уреаплазмы присутствуют, но концентрация незначительна;
- больше 104 КОЕ/мл – уреаплазмы обнаружены в концентрации больше 104 копий в 1 мл образца.
Особенности
Ureaplasma urealyticum принадлежит к числу Т-микоплазм. Данные микроорганизмы начинают развиваться при температуре 37 градусов. Их росту препятствует жидкая среда обитания. Главная особенность уреаплазм — высокая потребность в лимитных веществах (например, холестерин) и мочевине. Расщепляют мочевую кислоту до аммиака. Микроорганизмы стимулируют воспалительные процессы органов мочеполовой системы.
В женском организме уреаплазмы являются представителями условно-патогенной микрофлоры. Их вредоносные свойства проявляются под влиянием одного из провоцирующих факторов. Взаимодействие уреаплазм с прочими микробами может привести к развитию ряда заболеваний, требующих немедленного медикаментозного вмешательства. Важно заметить, что этот микроорганизм отличается высокой устойчивостью к большинству современных антибиотиков в силу отсутствия клеточной стенки.
Характер терапии зависит от индивидуальных особенностей, поэтому лечение должно назначаться исключительно лечащим врачом на основании исследовательских данных. Неправильная терапия лишь ослабит иммунитет, что может привести к необратимым последствиям.
Инкубационный период уреаплазмоза достаточно длительный. Это зависит от общего состояния иммунной системы. По статистике он может длиться более пяти недель.
На сегодняшний день не доказано, что уреаплазмы могут передаваться здоровому человеку посредством бытового контакта (стульчак в общественном туалете, полотенца и прочие). К основным факторам риска относятся:
- ранняя половая активность;
- частая смена партнеров;
- нетрадиционный половой акт;
- отсутствие средств контрацепции;
- радиоактивное облучение;
- чрезмерное употребление гормональных препаратов и ряд прочих факторов, негативно влияющих на иммунную систему.
Согласно статистическим данным, от уреаплазмоза страдает более 60% населения в возрасте до 30 лет.
Уреаплазма у женщин – лечение
При диагнозе уреаплазмоз лечение проводится комплексно. Женщине показано прохождение специализированного курса терапии, который осуществляется специалистом по половым инфекциям. Основу лечения составляет антибактериальная терапия, которая дополняется назначением препаратов, улучшающих иммунитет. Важное значение имеет совместное лечение обоих половых партнеров, что исключает повторное инфицирование. Как лечить уреаплазму в конкретной ситуации, способен определить только врач.
Лечение уреаплазмоза у женщин – препараты
Чтобы во влагалищной микрофлоре не присутствовала в большом количестве уреаплазма, лечение заболевания строят на приеме антибиотиков. Активность лекарственного средства в отношении патогена определяется минимальной подавляющей концентрацией при проведении исследований invitro. При лечении уреаплазмоза предпочтение отдают препаратам, которые воздействуют на синтез белка генетического материала бактерий, тем самым замедляя их рост и развитие (бактериостатический эффект). В отношении уреаплазм высокую эффективность показывают следующие препараты:
- макролиды, линкозамины, стрептограмины: Эритромицин, Олеандомицин, Спирамицин, Джозамицин, Мидекамицин;
- фторхинолоны: Офлоксацин, Ципрофлоксацин;
- аминогликозиды: Стрептомицин, Канамицин.
Лечение уреаплазмоза у женщин – схема
Чтобы поскорее ликвидировать уреаплазмоз, лечение у женщин данного заболевания осуществляют по установленным схемам. Подбор лекарства, дозировки, кратности приема устанавливается врачом индивидуально. При этом существуют часто используемые схемы, доказавшие свою эффективность в лечении заболевания. В качестве примера можно привести следующие варианты терапии:
- Кларитромицин
по 250 мг дважды в день, 7–14 дней; - Джозамицин (вильпрафен)
– 500 мг трижды в день, 7–14 дней; - Азитромицин
– по 250 мг 3 раза в сутки 6 дней или 1 г антибиотика однократно.
Лечение уреаплазмоза народными средствами
В качестве дополнительных методов терапии врачи нередко проводят лечение уреаплазмоза с помощью лекарственных трав. Оно направлено на улучшение самочувствия женщины, повышение защитных сил, ликвидацию симптоматики. Чтобы избежать ухудшения ситуации, средства можно использовать только после одобрения врача и согласно его рекомендациям. В качестве примера можно привести следующие рецепты.
Лекарственный сбор
Ингредиенты:
- зверобой – 2 ст. ложки;
- цветки лабазника вязолистного – 4 ст. ложки;
- вода – 800 мл.
Приготовление, применение
- Сырье смешивают.
- 4 ст. ложки смеси заливают кипятком и кипятят 10 минут.
- Настаивают 2 часа.
- Процеживают и принимают по 1 стакану 3-4 раза в день, за 15 минут до приема пищи.
Отвар от уреаплазмоза
Ингредиенты:
- зверобой – 2 ст. ложки;
- кора бузины – 3 ст. ложки;
- корни бузины травянистой – 3 ст. ложки.
Приготовление, применение
- Ингредиенты тщательно смешивают.
- 4 ст. ложки смеси заливают кипятком и кипятят 10–15 минут.
- Настаивают 1 час.
- Используют для ванночек 1-2 раза в день.
Диагностические методы
Обязательному обследованию на предмет уреаплазмоза подлежат следующие лица: молодая семья, планирующая обзавестись потомством; люди с хроническими заболеваниями органов мочеполовой системы; женщины в период беременности; при подозрении на наличие возбудителя венерических заболеваний.
На сегодняшний день существует несколько диагностических методов, позволяющих выявить у пациента уреаплазменную инфекцию. Среди них можно выделить:
- Бактериологический посев. Размер уреаплазм предельно мал, поэтому классической микроскопии недостаточно для точной диагностики. Взятый из влагалища мазок в большинстве случаев указывает на смешанную микрофлору с преобладающим в ней числом стафилококков и стрептококков, при этом уреаплазмы остаются незамеченными. Данный метод позволяет определить количество вредоносных микроорганизмов, а также проанализировать их чувствительность к антибиотикам. Если отсутствуют видимые симптомы, то допустимым числом уреаплазм в микрофлоре влагалища является десять в четвертой степени КОЕ/мл. Результаты данного исследования придется ждать довольно долго (около недели), поэтому при ярко выраженной симптоматике лечащий врач может направить на прохождение альтернативной диагностической процедуры — полимерной цепной реакции (ПЦР);
- Молекулярно — биологическое исследование или ПЦР. Самый точный, относительно быстрый (экспертиза занимает около пяти часов) и наиболее распространенный из всех современных методов диагностики данного заболевания. Материалом для исследования могут быть: секрет предстательной железы, эякулят, моча, мазок из влагалища. При выявлении ДНК уреаплазмы прочие исследования не будут иметь смысла. Результат данного анализа не оспаривается;
- Серологическая диагностика. Анализ представляет собой иммуноферментный анализ. Проверяется реакция на прямую и непрямую иммунофлюоресценцию;
- Общие анализы крови и мочи. Являются первостепенными и обязательными диагностическими методами. Их биологический состав укажет на воспалительный процесс в организме при его наличии;
- Кольпоскопия. Данный механический метод исследования направлен на выявление патологических изменений в слизистых оболочках органов мочеполовой системы. Это исследование является вспомогательным и может быть назначено лечащим врачом для окончательного подтверждения диагноза.
Количество уреаплазм у женщин, выявленное при сдаче анализов, не должно превышать допустимых значений. В противном случае лечение антибиотиками является обязательным. Его курс должен быть не менее одной недели.
При обследовании может быть также выявлен микроорганизм под названием ureaplasma urealyticum parvum — более вредоносная разновидность уреаплазм, гораздо тяжелее поддающаяся терапии.
Уреаплазма при беременности
Во время планирования беременности обследование на уреаплазму является обязательным. Если перед зачатием женщина прошла все необходимые исследования, то риск того, что возникнет уреаплазмоз при беременности, снижается в несколько раз. Однако полностью исключить возможность заболевания нельзя, поэтому врачи проводят тщательный контроль и наблюдение за беременными. Повышенное внимание к заболеванию обусловлено риском развития осложнений, среди которых:
- цервикальная недостаточность;
- выкидыш;
- хорионамниониты;
- рождение детей с недостаточной массой тела.
Лечение уреаплазмоза при вынашивании плода имеет свои особенности. При назначении препарата врачи обращают внимание на срок гестации, общее состояние матери и ребенка. На ранних сроках лечение антибиотиками запрещено, поэтому врачи занимают выжидательную тактику до 14-17 недели. С этого времени назначают щадящую антибиотикотерапию, целью которой является недопущение инфицирования плода и предупреждение осложнений беременности.
Профилактика уреаплазмоза
Профилактические мероприятия, предупреждающие развитие уреаплазмоза и прочих заболеваний, передающихся половым путем:
- Использование презервативов.
- Применение после полового акта антисептических растворов – «Мирамистина», «Хлоргексидина», свечей – «Полиженакс», «Гексикон».
- Укрепление иммунитета.
- Гигиена половых органов.
- Периодическое обследование на ИППП.
Ureaplasma urealyticum — возбудитель типичного венерического заболевания, требующего лечения во избежание осложнений и распространения половой инфекции в социуме.